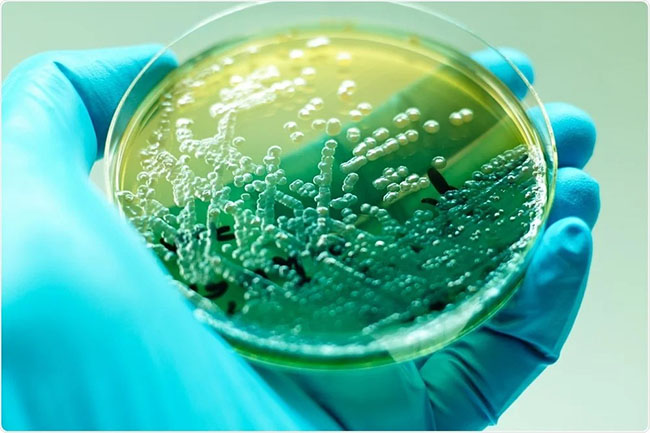
Vi khuẩn Pseudomonas thích nghi và hoạt động tốt trong nhiều môi trường, có khả năng lội tốt trong nước.

Vi khuẩn Pseudomonas là chủng vi sinh không thể thiếu trong quá trình xử lý nước thải bằng phương pháp sinh học. Vậy chủng vi khuẩn này có đặc điểm gì? Chúng đóng vai trò gì trong quá trình xử lý nước thải? Bài viết sau sẽ giúp bạn hiểu rõ hơn về chủng vi khuẩn Pseudomonas này.

Vi khuẩn Pseudomonas là gì?
Vi khuẩn Pseudomonas thuộc nhóm vi khuẩn Gram âm, tế bào có dạng hình que, sống tự do và có mặt ở khắp nơi như nước, đất, thực vật, động vật.
Sự biến dưỡng dễ thay đổi và tính linh hoạt của vi khuẩn Pseudomonas đã giúp chúng có thể tồn tại bền bỉ trong nhiều điều kiện môi trường. Đây cũng là một loại tiêu biểu, được ứng dụng trong những công nghệ sinh học cho nhiều lĩnh vực trong đời sống.
Vi khuẩn Pseudomonas có đặc điểm sinh lý là dị dưỡng, không lên men, linh hoạt trong dinh dưỡng, không quang hợp hay cố định Nitrogen.

Hình 1. Vi khuẩn Pseudomonas có cấu trúc dạng hình que, tồn tại ở khắp mọi nơi, hoạt động mạnh mẽ trong nhiều điều kiện môi trường.
Đặc điểm của vi khuẩn Pseudomonas
Vi khuẩn Pseudomonas đã trở thành một trong những loài vi sinh vật không thể thiếu khi xử lý nước thải bằng phương pháp sinh học nhờ vào những đặc điểm sau:
- Thích nghi và hoạt động tốt trong cả ba môi trường: Hiếu khí, kỵ khí và tùy nghi. Có khả năng hô hấp hiếu khí hay kỵ khí tại những môi trường không có oxy.
- Có khả năng lội tốt trong nước nhờ có roi mào ở cực, không có khả năng tạo ra bào tử.
- Có khả năng lên men được nhiều loại đường, tạo nhiều màng nhầy nhờ hoạt tính Amylaza và Proteaza có trong vi khuẩn Pseudomonas.
- Sở hữu khả năng phân hủy tinh bột, Protein mạnh mẽ.
Hình 2. Vi khuẩn Pseudomonas thích nghi và hoạt động tốt trong nhiều môi trường, có khả năng lội tốt trong nước.
Những yếu tố ảnh hưởng đến khả năng hoạt động của vi khuẩn Pseudomonas:
- Vi khuẩn Pseudomonas phát triển thuận lợi trong khoảng nhiệt độ từ 30 – 37 độ C.
- Trong môi trường có độ pH dưới 5 sẽ kìm hãm sự phát triển của vi khuẩn Pseudomonas, kìm hãm sinh tổng hợp Proteaza.
- Vi khuẩn Pseudomonas bị ngưng trệ khi nồng độ muối trong nước từ 5 – 6%.
Vai trò của vi khuẩn Pseudomonas trong quá trình xử lý nước thải
Sở hữu những đặc tính vượt trội, cùng khả năng phân hủy, hoạt động tốt trong nhiều môi trường, vi khuẩn Pseudomonas đóng vai trò vô cùng quan trọng, góp phần tạo ra hiệu quả tối đa trong quá trình xử lý nước thải bằng phương pháp sinh học.
Vai trò quan trọng của vi khuẩn Pseudomonas trong quá trình xử lý nước thải có thể kể đến là:
- Tổng hợp các Enzyme để thúc đẩy quá trình phân hủy các chất hữu cơ trong nước. Vi khuẩn này có thể đồng hóa tốt được mọi chất hữu cơ, ngay cả những hợp chất hữu cơ khó phân hủy, tồn tại lâu trong môi trường nước.
- Tham gia quá trình oxy hóa khử do hệ Enzyme làm nội bào xúc tác, cho ra sản phẩm cuối là nước (H2O) và CO2.
- Tham gia vào quá trình chuyển hóa Nitrat thành phân tử Nitơ trong không khí, giúp giảm nồng độ của Nitơ tổng, Amoni, Nitrit, Nitrat trong hệ thống nước thải. Quá trình này diễn ra theo hai bước: Chuyển hóa Nitrat (NO3-) thành Nitrit (NO2-), sau đó tạo ra Nitơ Oxit(NO), Đinitơ Oxit (N2O) và khí Nitơ (N2).

Hình 3. Vi khuẩn Pseudomonas đóng vai trò quan trọng, góp phần tăng hiệu quả của quá trình xử lý nước thải.
Ứng dụng vi khuẩn Pseudomonas vào Men vi sinh xử lý nước thải Microbe-Lift IND
Chủng vi sinh vật Pseudomonas có nhiều chức năng vượt bậc, đóng góp to lớn cho quá trình xử lý nước thải đạt hiệu quả tối đa. Dựa vào những chức năng này, Viện Nghiên Cứu Sinh Thái Hoa Kỳ (Ecological Laboratories INC.) đã tiến thành thực hiện nghiên cứu, phân lập với kỹ thuật và công nghệ độc quyền, tạo nên một sản phẩm men vi sinh Microbe-Lift IND ưu việt nhất trên thị trường.
Sản phẩm men vi sinh Microbe-Lift IND gồm tập hợp 13 chủng vi sinh vật khác nhau, kết hợp và hỗ trợ để phát huy hiệu quả xử lý nước thải tối đa. Ngoài Pseudomonas, Microbe-Lift IND còn bao gồm cả những chủng vi sinh vật điển hình cho quá trình xử lý nước thải, ví dụ như: Bacillus, Clostridium, Desulfovibrio, Geobacter… cùng nhiều hoạt chất mạnh mẽ khác. Microbe-Lift IND là một sản phẩm chủ lực, nổi trội của thương hiệu Microbe-Lift, có ứng dụng của vi khuẩn Pseudomonas.
– Điểm khác biệt của vi khuẩn Pseudomonas có trong sản phẩm men vi sinh Microbe-Lift IND:
- Chủng vi khuẩn được sản xuất ở dạng lỏng, đảm bảo khả năng hoạt động đến 100% khi xử lý nước thải.
- Thích nghi tốt ở cả 3 điều kiện môi trường: Hiếu khí, kỵ khí và tùy nghi.
- Có khả năng xử lý tốt các nguồn nước thải có tải trọng ô nhiễm cao, như: nước thải trong ngành công nghiệp cao su, dệt nhuộm, chế biến thực phẩm, sản xuất bia, sản xuất nước giải khát, sản xuất dầu ăn,…
- Ứng dụng cho đa dạng các loại nước thải, từ nước thải sinh hoạt, khu đô thị, dân cư, chung cư cao tầng đến các loại nước thải từ trung tâm thương mại, nhà hàng, khách sạn, công nghiệp hay chế biến thủy sản.

Hình 4. Men vi sinh Microbe-Lift IND chứa vi khuẩn Pseudomonas được ứng dụng phổ biển trong xử lý nhiều loại nước thải khác nhau.
Microbe-Lift IND được ứng dụng rộng rãi trong xử lý nước thải công nghiệp, nước thải sinh hoạt, chăn nuôi, cao su, thủy sản, tinh bột mì… Sản phẩm men vi sinh này đóng vai trò quan trọng trong xử lý BOD, COD, TSS trong nước thải, có khả năng hoạt động gấp 5 – 10 lần so với các vi sinh thông thường. Ứng dụng vi khuẩn Pseudomonas vào Microbe-Lift IND còn giúp tăng cường, thúc đẩy quá trình khử Nitrat, giảm lượng Nitơ tổng, Amoni, Nitrit và Nitrat.
—
Ứng dụng vi khuẩn Pseudomonas trong xử lý nước thải ngày càng nhiều. Hiểu được đặc tính, vai trò của vi sinh vật giúp người dùng tận dụng được tối đa các chức năng của vi khuẩn để đạt được hiệu quả xử lý nước thải tối đa nhất. Nếu có bất kỳ thắc mắc nào hoặc cần tư vấn về men vi sinh Microbe-Lift IND chứa chủng vi khuẩn Pseudomonas, hãy liên hệ Biogency theo HOTLINE 0909 538 514 để được tư vấn chi tiết.
>>> Xem thêm: Những chủng vi sinh vật xử lý nước thải hiệu quả nhất!
